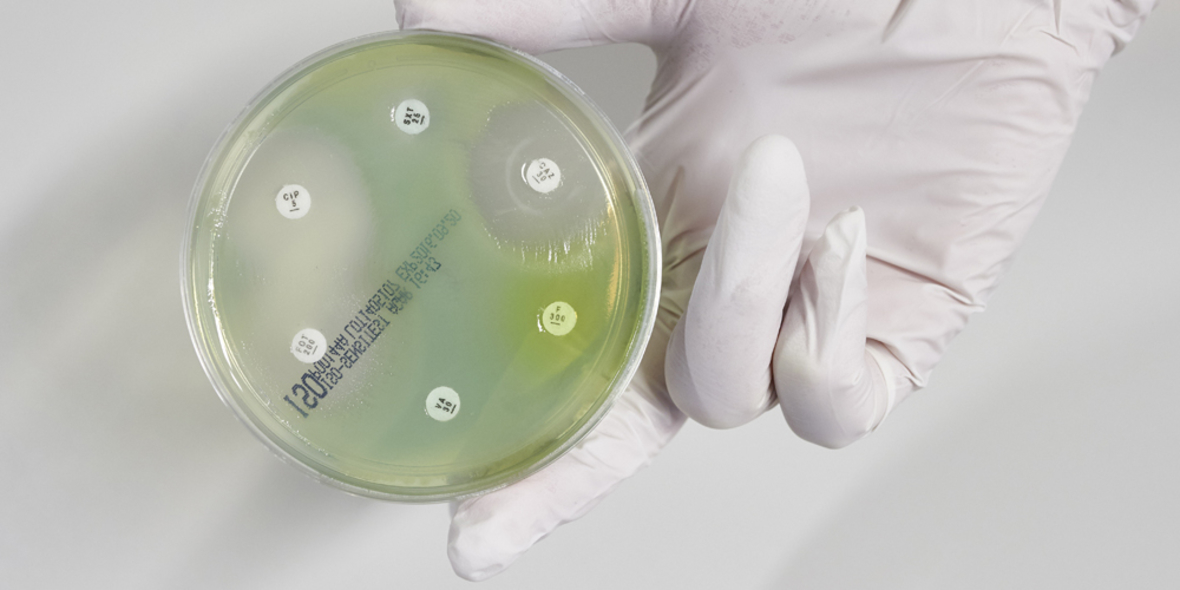
Tödliche Erreger in Pharma-Wirkstoffen – Verantwortung geht anders!

Tödliche Erreger in Pharma-Wirkstoffen – Verantwortung geht anders!
Schauen deutsche Unternehmen bei Produktionen im Ausland weg? Recherchen von NDR, WDR und Süddeutscher Zeitung haben ergeben, dass durch die Abwasserbelastung auf Grund von hohen Mengen Antibiotika rund um die Pharmafabriken der indischen Stadt Hyderabad die Gefahr von multiresistenten Supererregern besteht. Ursache dafür ist unter anderem eine mangelnde Abwasserreinigung bei der Herstellung. Dies bedeutet eine extrem hohe Gefährdung der dortigen Bevölkerung. Das Problem: Viele deutsche Pharmaunternehmen wie Ratiopharm, Hexal oder Stada beziehen ihre Wirkstoffe aus Hyderabad.
05.05.2017

Wie häufig in solchen Fällen üblich, verweisen die Unternehmen auf ihre Standards und Kontrollen. Allerdings überwachen diese Kontrollen in aller Regel nur den Produktionsprozess innerhalb der Fabriken. Es ist immer wieder zu beobachten, dass große Konzerne, die im Ausland produzieren, sich anscheinend nicht besonders intensiv um die Herstellungsbedingungen und die sozialen und ökologischen Auswirkungen der Produktion ihrer Produkte kümmern. Denn Wegsehen bedeutet oft eine nicht zu unterschätzende Kostenersparnis. Und wird über Missstände berichtet, so wird in schöner Regelmäßigkeit erst einmal von allen Seiten abgewiegelt und auf irgendwelche ominöse Kontrollen und Standards hingewiesen. Mit verantwortungsvollem und sozialem Unternehmertum hat das allerdings nichts zu tun.
Dass es auch anders gehen kann, beweisen mittelständische Unternehmen wie das Hosenatelier Gardeur aus Mönchengladbach, welches seine Hosen bereits seit vielen Jahren in eigenen Werken in Tunesien produzieren lässt. Inhaber und Geschäftsführer Gerhard Kränzle hat eine klare Vorstellung von Verantwortung bei der Produktion: "Ein gut organisiertes Produkt darf der Umwelt nicht schaden." Die Produktionsstätten von Gardeur in Tunesien sind ISO-zertifiziert und entsprechen deutschem Standard. Es gibt eine eigene Kläranlage, durch die das Wasser in Trinkqualität wieder in den Kreislauf gegeben wird. Auch die gezahlten Löhne liegen dort 20 Prozent über dem tunesischen Durchschnittseinkommen.
Gardeur ist ein positives Beispiel für ein deutsches Unternehmen, das mit seiner Produktion im Ausland soziale und ökologische Verantwortung übernimmt. Auch junge Start-up-Unternehmen wie der Kondomhersteller Einhorn aus Berlin übernehmen Verantwortung für die Produktion des benötigten Rohstoffs Kautschuk in Malaysia. Die Geschäftsführer Waldemar Zeiler und Philip Siefer reisen regelmäßig nach Malaysia, um die nachhaltige Gewinnung auf den Kautschukplantagen zu überwachen und zu fördern. Große Teile der Gewinne werden in entsprechende soziale und nachhaltige Projekte reinvestiert.
Es ist immer wieder erstaunlich, dass es kleinen und mittleren Unternehmen gelingt, soziale und ökologische Verantwortung zu übernehmen, und großen Konzernen, die erheblich mehr Mittel besitzen, dies große Mühe bereitet. Kläranlagen in Indien sind mit Sicherheit nicht so teuer, dass sie die Produkte hier in Deutschland immens verteuern würden. Sie würden aber dazu beitragen, Menschenleben zu retten.


